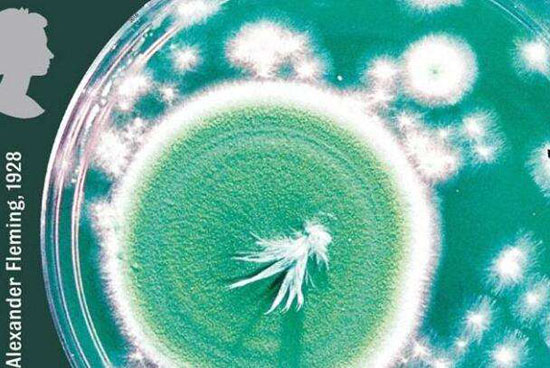

详细内容
新研究称,细菌能“吃”青霉素的秘密揭开
时间:2018-05-14 【转载】 来自于:人民健康网
青霉素等抗生素常被用于对付细菌,但现在一些细菌不仅对抗生素产生了耐药性,甚至还能以抗生素为食。一项最新研究揭开了细菌为何能“吃”青霉素的秘密,相关发现有助于解决抗生素污染问题。
美国圣路易斯华盛顿大学医学院等机构的研究人员近日在英国《自然·化学生物学》杂志上发表的论文说,他们分析了4种能“吃”青霉素的土壤细菌,发现有3组基因在这个过程中发挥重要作用。在这些基因的作用下,细菌会先释放β-内酰胺酶,以此使青霉素失去杀菌能力,然后再释放一种特殊的酶,用于将青霉素分解为可供“食用”的物质。整个过程就像有经验的厨师处理河豚一样,先去除毒素,然后享用美食。
青霉素是人类最早发现的抗生素,曾在卫生领域发挥巨大作用。但随着细菌耐药性增强,包括青霉素在内的许多抗生素作用越来越有限。近来人类研发新型抗生素的速度已经跟不上细菌产生耐药性的速度,这被视为全球卫生领域的严峻挑战。细菌产生耐药性的原因包括滥用抗生素、药厂废水乱排等。大量抗生素通过各种方式进入土壤和水源等环境中,导致越来越多的细菌产生耐药性。
研究人员称,了解细菌如何“吃”青霉素的机制,有助于研发新型抗生素,还能帮助解决抗生素污染问题。由于仅靠环境中天然存在的某些细菌难以有效消除抗生素污染,他们认为可用基因改造等方法,使大肠杆菌获得“吃”抗生素的能力,然后在有需要的地方投放这些细菌,帮助清除土壤和水源中的抗生素污染。(人民健康网)





